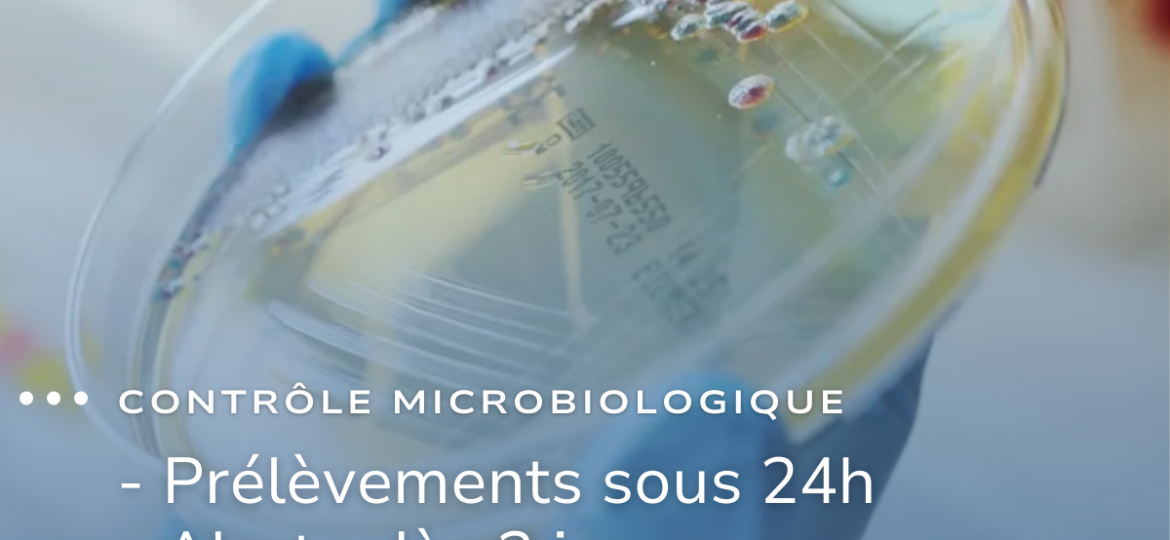
Contrôle microbiologique gagnez en réactivité, sécurisez vos environnements

En pharmacie, la performance ne se limite pas à l’accueil des patients.Elle se joue aussi derrière les murs. C’est précisément…
Il y a quelques semaines, nous vous mettions sur la piste. Aujourd’hui, on peut enfin vous l’annoncer officiellement…🎉 Eolia ouvre…
Un levier clé de performance et d’hygiène : Et si vos réseaux aérauliques cachaient un vrai levier de performance ?…
Pour la 5ème année consécutive, Eolia Groupe figure dans le classement des champions de la croissance 2026 publié par Les…
Chez Eolia Groupe, nous sommes convaincus que la prise en charge des patients atteints de cancer ne se limite pas…
Parce que l’air pur commence… dans les endroits que l’on oublie ! Le constat : Vos équipements de traitement d’air…
Pourquoi le rétrofit ? Réhabiliter l’existant à neuf, augmenter les performances, sans perturbation de l’activité, tout en réduisant les coûts…
Chez Eolia groupe, nous avons fait le choix d’un laboratoire de microbiologie internalisé pour vous offrir plus de réactivité dans…
Jeudi 6 novembre, nous avons eu le plaisir de participer à la collecte des déchets organisée par La Ciotat entreprendre….
🔬 Notre laboratoire d’analyses microbiologiques à l’honneur ! Nous sommes fiers de voir notre laboratoire d’analyses microbiologiques mis en avant…